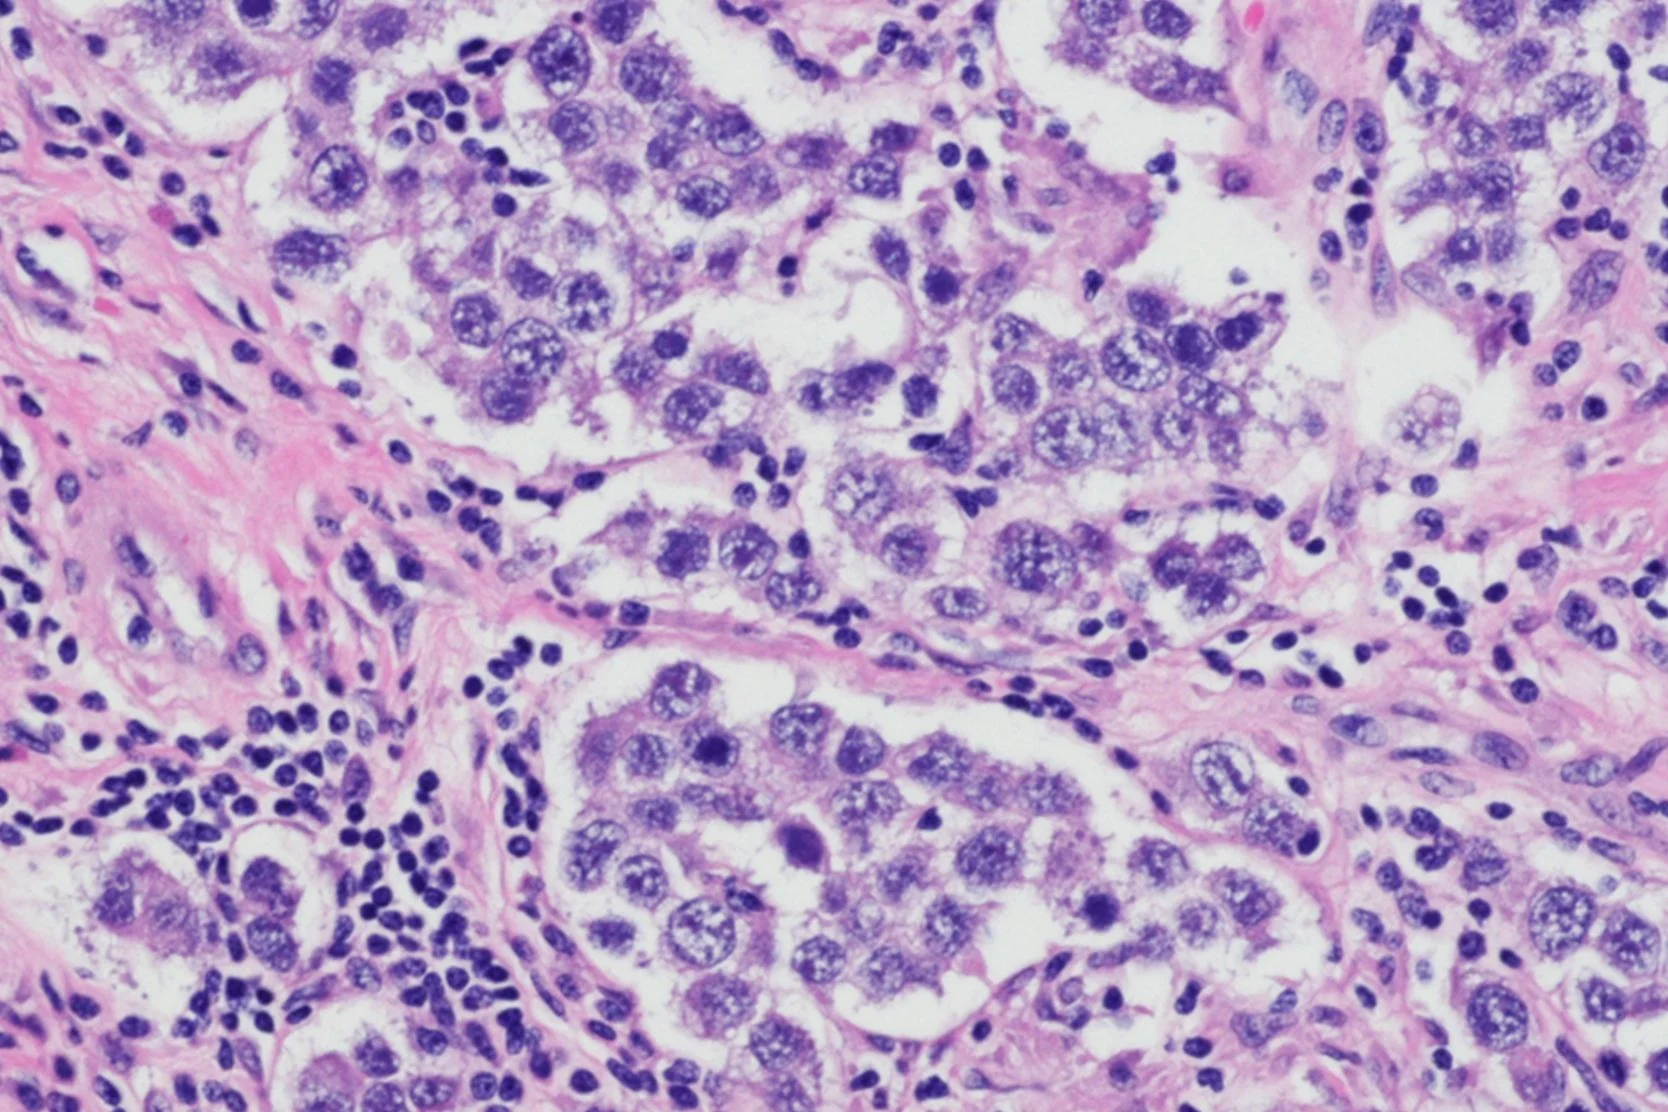

Taking Charge: How Is Ovarian Cancer Diagnosed?
Imaging and biopsies help doctors diagnose ovarian cancer. Understand these tests and what to expect if your provider thinks you may have ovarian cancer.
If your doctor thinks you may have ovarian cancer, you will be referred to someone who specializes in this disease. Usually that is a gynecologic oncologist, a surgeon who is specially trained in treating cancers of the female reproductive tract.
Imaging and diagnostic studies that you may undergo include:
- UltrasoundUltrasound is an imaging technique that uses sound waves to create a picture on a video screen. The waves are released from a small probe placed in the vagina or on the surface of the abdomen.
A special kind of ultrasound, color-flow Doppler, is sometimes used to measure blood flow to the ovaries. Blood flow is usually increased in ovarian cancers, although it may also be increased by other benign conditions. - Computed Tomography (CT scan)In this study, an X-ray beam rotates around the body, taking images at various angles. A computer compiles the images into a 3-D picture of the pelvis.
- Magnetic Resonance Imaging (MRI)This study uses magnetic fields and a computer to produce detailed, 3-D images of the pelvis. The procedure uses no X-rays.
- Tissue Sampling (Biopsy)Taking a sample of tissue and examining it under a microscope is the only way to be sure that a growth is cancer. Biopsy is usually performed at the time of surgery.
In rare cases, the biopsy sample can be taken by inserting a needle into the pelvis, with the guidance of computed tomography or ultrasound, and withdrawing some fluid that has collected in the abdomen (a condition called ascites).
Read More
- Next section of Taking Charge: How Is Ovarian Cancer Treated?
Return to the Taking Charge Index
- What Is Breast Cancer?
- Breast Cancer Risk Factors
- If You Are at High Risk for Breast Cancer
- Screening for Breast Cancer
- How Is Breast Cancer Diagnosed?
- How Is Breast Cancer Treated?
- What Is Ovarian Cancer?
- Who Gets Ovarian Cancer?
- If You Are at High Risk for Ovarian Cancer
- Screening for Ovarian Cancer
- How Is Ovarian Cancer Diagnosed?
- How is Ovarian Cancer Treated?
- Living with Ovarian Cancer
- Diet, Lifestyle and Cancer
- Glossary of Terms
Recommended reading
UCSF Health medical specialists have reviewed this information. It is for educational purposes only and is not intended to replace the advice of your doctor or other health care provider. We encourage you to discuss any questions or concerns you may have with your provider.










